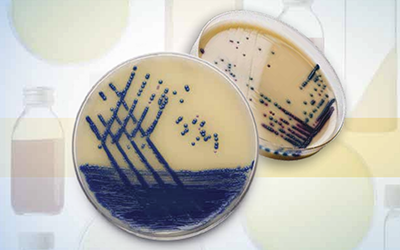

28.04.21. Оборудование для изучения поведения животных (стереотаксис, поведенческие тесты, системы анестезии, эвтаназии и другое). Системы содержания лабораторных грызунов и водных модельных организмов, часть 1
Бесплатный вебинар 28 апреля 2021 г.
Дата проведения:
Время проведения: